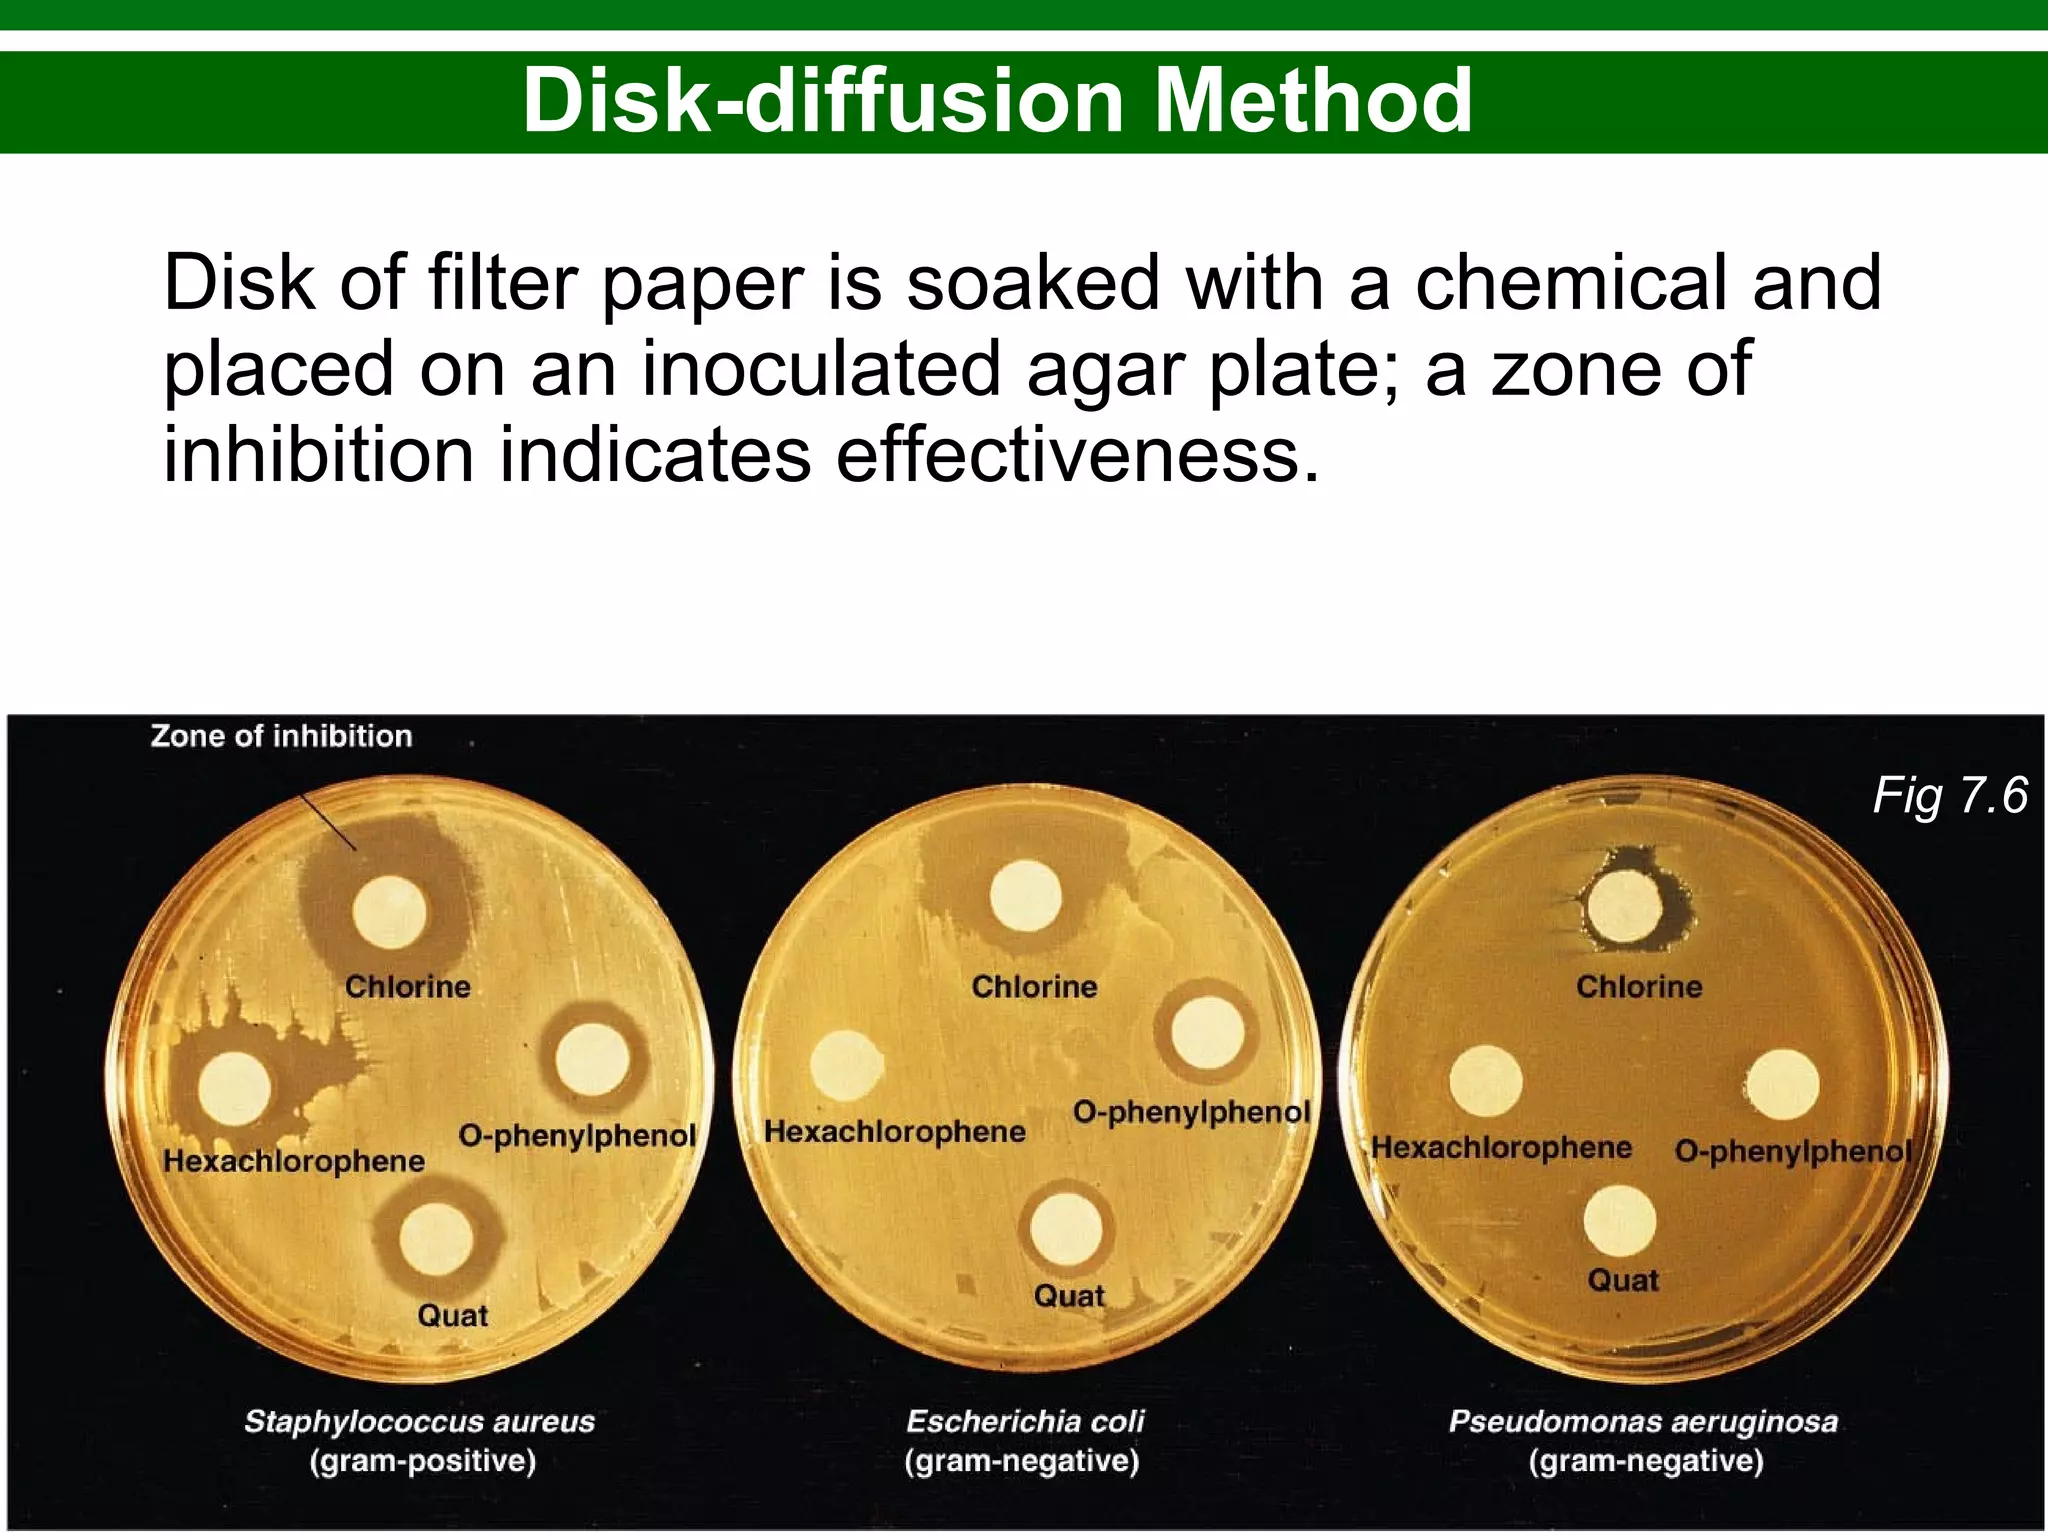
Copyright © 2010 Pearson Education, Inc.
Disk-diffusion Method
Disk of filter paper is soaked with a chemical and
placed on an inoculated agar plate; a zone of
inhibition indicates effectiveness.
Fig 7.6

This chapter discusses various methods for controlling microbial growth, including physical, chemical, and other approaches. It defines key terms and describes how different techniques like heat, radiation, filtration and chemicals impact microbial cells. Specific methods are outlined, such as how autoclaving, pasteurization, and dry heat kill microbes. The mechanisms and optimal uses of various disinfectants and antiseptics are also explained.